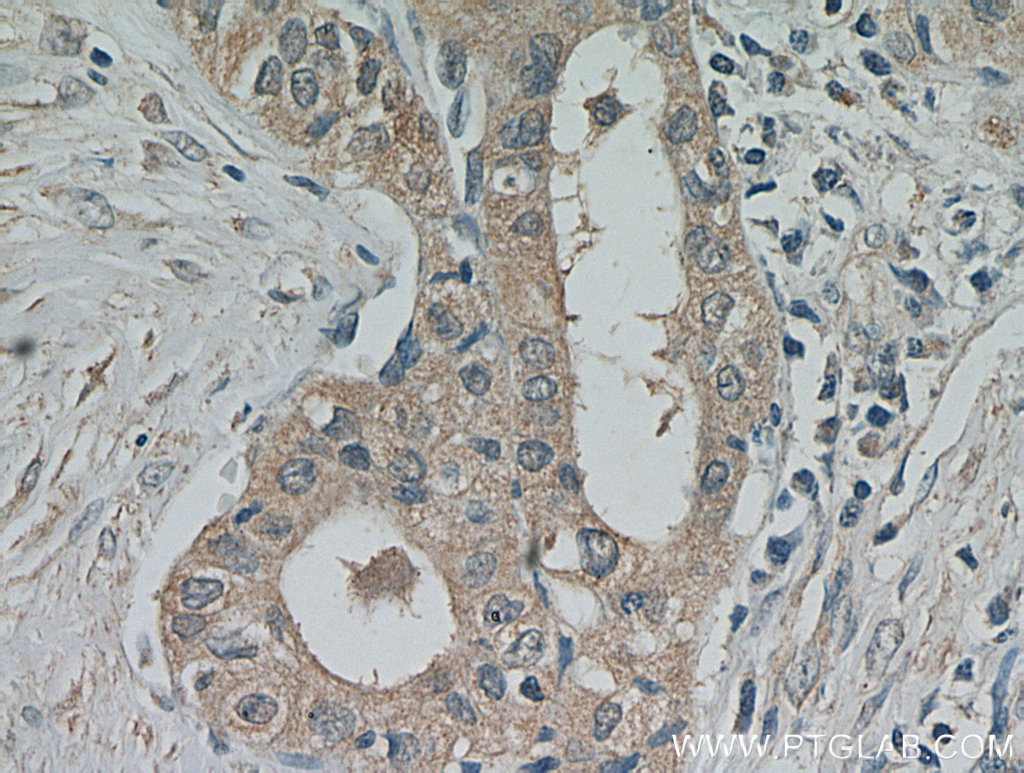

验证数据展示
经过测试的应用
| Positive WB detected in | mouse brain tissue, SH-SY5Y cells, rat brain tissue |
| Positive IP detected in | SH-SY5Y cells |
| Positive IHC detected in | mouse brain tissue, human thyroid cancer tissue Note: suggested antigen retrieval with TE buffer pH 9.0; (*) Alternatively, antigen retrieval may be performed with citrate buffer pH 6.0 |
| Positive IF-P detected in | mouse brain tissue |
| Positive IF/ICC detected in | HeLa cells, U2OS cells |
| Positive FC (Intra) detected in | Jurkat cells |
推荐稀释比
| 应用 | 推荐稀释比 |
|---|---|
| Western Blot (WB) | WB : 1:5000-1:50000 |
| Immunoprecipitation (IP) | IP : 0.5-4.0 ug for 1.0-3.0 mg of total protein lysate |
| Immunohistochemistry (IHC) | IHC : 1:50-1:500 |
| Immunofluorescence (IF)-P | IF-P : 1:50-1:500 |
| Immunofluorescence (IF)/ICC | IF/ICC : 1:50-1:500 |
| Flow Cytometry (FC) (INTRA) | FC (INTRA) : 0.40 ug per 10^6 cells in a 100 µl suspension |
| It is recommended that this reagent should be titrated in each testing system to obtain optimal results. | |
| Sample-dependent, Check data in validation data gallery. | |
产品信息
20877-1-AP targets PKC Epsilon in WB, IHC, IF/ICC, IF-P, FC (Intra), IP, ELISA applications and shows reactivity with human, mouse, rat samples.
| 经测试应用 | WB, IHC, IF/ICC, IF-P, FC (Intra), IP, ELISA Application Description |
| 文献引用应用 | WB, IHC, IF, IP |
| 经测试反应性 | human, mouse, rat |
| 文献引用反应性 | human, mouse, rat, hamster |
| 免疫原 |
CatNo: Ag14976 Product name: Recombinant human PRKCE protein Source: e coli.-derived, PGEX-4T Tag: GST Domain: 294-413 aa of BC109033 Sequence: VDARGIAKVLADLGVTPDKITNSGQRRKKLIAGAESPQPASGSSPSEEDRSKSAPTSPCDQEIKELENNIRKALSFDNRGEEHRAASSPDGQLMSPGENGEVRQGQAKRLGLDEFNFIKV 种属同源性预测 |
| 宿主/亚型 | Rabbit / IgG |
| 抗体类别 | Polyclonal |
| 产品类型 | Antibody |
| 全称 | protein kinase C, epsilon |
| 别名 | PRKCE, EC:2.7.11.13, nPKC-epsilon, PKCE, Protein kinase C epsilon type |
| 计算分子量 | 737 aa, 84 kDa |
| 观测分子量 | 84 kDa |
| GenBank蛋白编号 | BC109033 |
| 基因名称 | PKC Epsilon |
| Gene ID (NCBI) | 5581 |
| RRID | AB_10697812 |
| 偶联类型 | Unconjugated |
| 形式 | Liquid |
| 纯化方式 | Antigen affinity purification |
| UNIPROT ID | Q02156 |
| 储存缓冲液 | PBS with 0.02% sodium azide and 50% glycerol, pH 7.3. |
| 储存条件 | Store at -20°C. Stable for one year after shipment. Aliquoting is unnecessary for -20oC storage. |
背景介绍
PKC Epsilon (Protein kinase C epsilon type) is also named as PKC-ε, PRKCE and PKCE. It belongs to the protein kinase superfamily, AGC Ser/Thr protein kinase family and PKC subfamily. PKC-ε, one of the novel isoforms, as a critical player in membrane mobilization during phagocytosis (PMID: 9069266). KC-ε is tethered to the Golgi through binding of its pseudosubstrate domain to phosphatidylinositol-4-phosphate (PI4P) (PMID: 28539432). PKC-ε traffics on microtubule-associated vesicles from the Golgi to the forming phagosome. As the majority of macrophage PKC-ε is cytosolic, and PKCs translocate from the cytosol to their sites of activity, it predicted that cytosolic PKC-ε concentrated at phagosomes to facilitate membrane addition (PMID: 34622926). Two PKC isozymes of the novel group, PKCε and PKCδ, have different and sometimes opposite effects. PKCε stimulates cell growth and differentiation while PKCδ is apoptotic (PMID: 21810427).
实验方案
| Product Specific Protocols | |
|---|---|
| FC protocol for PKC Epsilon antibody 20877-1-AP | Download protocol |
| IF protocol for PKC Epsilon antibody 20877-1-AP | Download protocol |
| IHC protocol for PKC Epsilon antibody 20877-1-AP | Download protocol |
| IP protocol for PKC Epsilon antibody 20877-1-AP | Download protocol |
| WB protocol for PKC Epsilon antibody 20877-1-AP | Download protocol |
| Standard Protocols | |
|---|---|
| Click here to view our Standard Protocols |
发表文章
| Species | Application | Title |
|---|---|---|
Elife cAMP-EPAC-PKCε-RIM1α signaling regulates presynaptic long-term potentiation and motor learning | ||
Biochem Pharmacol Thromboxane A2-TP axis promotes adipose tissue macrophages M1 polarization leading to insulin resistance in obesity | ||
J Cell Mol Med Protein kinase C is involved in the neuroprotective effect of berberine against intrastriatal injection of quinolinic acid-induced biochemical alteration in mice. | ||
Fish Shellfish Immunol In vivo study of a novel protein kinase C that mediates immunocompetence and catecholamine biosynthesis in hemocytes of Litopenaeus vannamei by using its potential competitive inhibitor, bisindolylmaleimide I. | ||
Mol Biol Cell MiR-34a regulates blood-tumor barrier function by targeting protein kinase Cɛ. | ||
Oxid Med Cell Longev p66Shc Mediates Mitochondrial Dysfunction Dependent on PKC Activation in Airway Epithelial Cells Induced by Cigarette Smoke. |